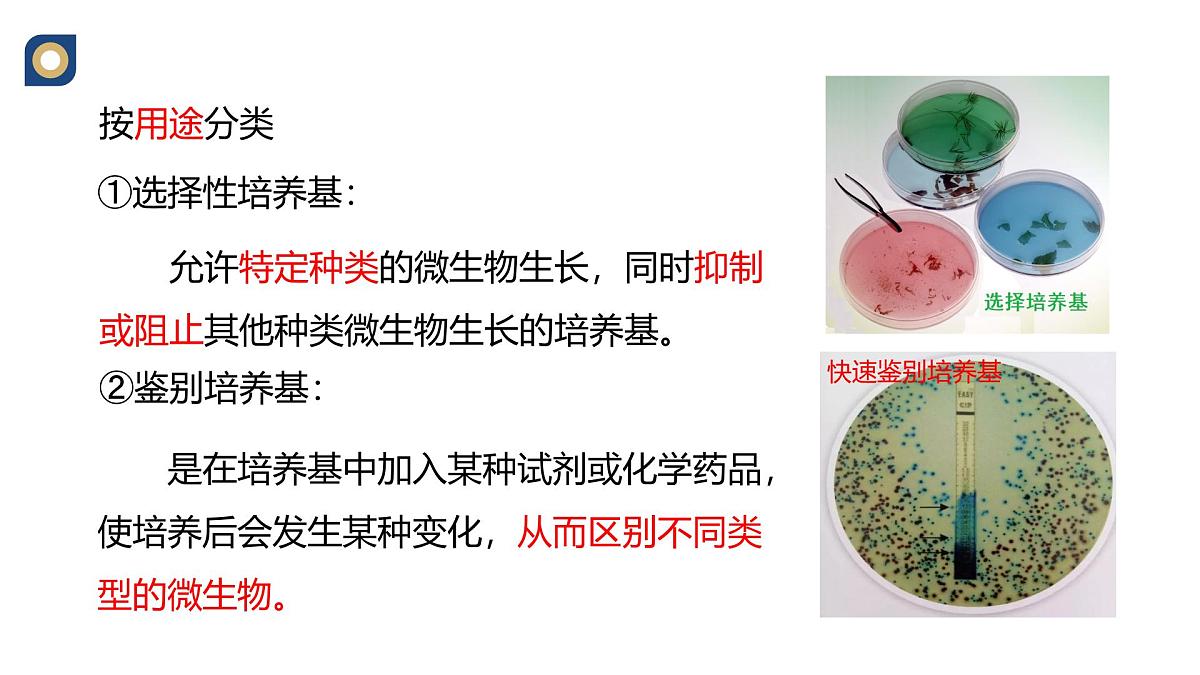
人教版高中生物选修3 1-2《微生物的基本培养技术（第1课时）》教学课件第8页

所属成套资源:人教版高中生物选修3 课件+教案+试题
高中生物人教版 (2019)选择性必修3微生物的基本培养技术教学课件ppt
展开
这是一份高中生物人教版 (2019)选择性必修3微生物的基本培养技术教学课件ppt,共19页。PPT课件主要包含了从社会中来,微生物,非细胞类,霉菌等,原生生物,类病毒等,培养基,无菌技术,基本成分,1碳源等内容,欢迎下载使用。
向经过杀菌处理的牛奶中添加某些对人体有益的细菌,再经过发酵就可以制成酸奶。一般家庭自制酸奶可能会导致肠胃不适,主要原因是有杂菌混入。 那么怎么才能保证无处不在的杂菌不混入发酵物中呢?
这需要应用无菌技术和微生物的培养技术。
微生物:指一切肉眼看不见或看不清楚的个体微小、结构简单的微小生物的总称。
细菌、放线菌、支原体、蓝藻等
草履虫、变形虫、衣藻等
实验室培养微生物条件:
(1)提供微生物生长繁殖所需营养和环境条件
(2)确保其它微生物无法混入
动物需从食物中获得物质和能量,植物也需吸收水等才能进行光合作用,哪微生物生存繁殖,需要“吃”什么?
1.思考下列问题:(1)培养基的作用有哪些?(2)培养基中要包含哪营养物质?(3)培养基的种类有哪些?
CO2、CO32-、HCO3-
人们按照微生物对营养物质的不同需求,配置出的供其生长繁殖的营养基质。
水、碳源、氮源、无机盐
NH4+、NO3- 、N2 等
牛肉膏、蛋白胨、酵母膏、尿素等
含CHON的有机物是异养型微生物的碳源、氮源、能源。
维生素、碱基等(生长因子)
(牛肉膏、酵母膏、蛋白胨中含有)
3.pH、氧气的需求:
在满足四种主要营养物质的基础上,培养基还需要满足微生物对_____、_____________以及_______的特殊要求。
(1)液体培养基
配制成的液体状态的基质。
在液体培养基中加入凝固剂(如琼脂),配制成的固体状态的基质。琼脂固体培养基是实验室中最常用的培养基之一。
允许特定种类的微生物生长,同时抑制或阻止其他种类微生物生长的培养基。
是在培养基中加入某种试剂或化学药品,使培养后会发生某种变化,从而区别不同类型的微生物。
牛肉膏蛋白胨培养基是一种应用最广泛和最普通的细菌基础培养基。
获得纯净培养物的关键是防止外来杂菌的入侵。
使用较为温和的物理或化学方法杀死物体表面或内部的部分微生物(不包括芽孢和孢子)
用强烈的理化因素杀死物体内外所有的微生物,包括芽孢和孢子
思考下列问题:(1)消毒与灭菌的目的是什么?(2)消毒与灭菌的区别是什么?(3)消毒与灭菌的对象有哪些?(4)消毒有哪些方法?(5)灭菌常见的方法有哪些?
无菌技术泛指在培养微生物的操作中,避免杂菌污染的方法。
④紫外线消毒法:(如超净工作台)
100℃煮沸5-6min
70-75℃下煮30min 或 80℃下煮15min(适用于不耐高温的液体)
酒精擦拭双手、氯气用于水源消毒等。
紫外线照射30min杀死物表或空气的微生物。
100KPa,121℃下维持15-30min
适用于能耐高温、需要保持干燥的物品160-170℃加热1-2小时。
接种工具、试管口等易被污染物品或部位。
1.细菌培养过程中分别采用了高压蒸汽、酒精、火焰灼烧等几种不同的处理方法,这些方法依次用于杀灭哪些部位的杂菌( )A.接种针、手、培养基B.高压锅、手、接种针C.培养基、手、接种针D.接种针、手、高压锅
2.下列关于微生物的营养的说法,正确的是( )A.同一种物质不可能既作碳源又作氮源B.凡是碳源都能提供能量C.除水以外的无机物仅提供无机盐D.无机氮源也可能提供能量
3.牛肉膏蛋白胨固体培养基叙述正确是( )A.牛肉膏和蛋白胨都能提供碳源、氮源、磷酸盐、维生素B.牛肉膏蛋白胨培养基需经高压蒸汽灭菌后调节pHC.该培养基配方中,有机物含量多、无机盐含量少D.该培养基中加入少量水即可制成液体培养基
4.下列是与微生物培养有关的问题,请回答:(1)某细菌固体培养基的组成成分是KH2PO4、Na2HPO4、MgSO4、葡萄糖、尿素、琼脂和蒸馏水,其中凝固剂是_______,碳源是_________,氮源是______。已知只有能合成脲酶的细菌才能在该培养基上生长,故该培养基属于_______培养基。从同化作用类型看,用该培养基培养的细菌属于_________。(2)通常情况下,在微生物培养过程中,实验室常用的灭菌方法有灼烧灭菌、_____________和______________。无菌技术要求实验操作应在酒精灯______附近进行,以避免周围环境中微生物的污染。
5.在生产、生活和科研实践中,经常通过消毒和灭菌来避免杂菌的污染。回答下列问题:(1)在实验室中,玻璃和金属材质的实验器具_____(填“可以”或“不可以”)放入干热灭菌箱中进行干热灭菌。(2)牛奶的消毒常采用巴氏消毒法或高温瞬时消毒法,与煮沸消毒法相比,这两种方法的优点是_________________________________________。(3)密闭空间内的空气可采用紫外线照射消毒,其原因是紫外线能________________, 在照射前,适量喷洒________,可强化消毒效果。(4)某同学在使用高压蒸汽灭菌锅时,若压力达到设定要求,而锅内并没有达到相应温度,最可能的原因是_________________________。
在达到消毒目的的同时,营养物质损失较少
相关课件
这是一份高中生物人教版 (2019)选择性必修3微生物的基本培养技术教学课件ppt,共19页。PPT课件主要包含了从社会中来,微生物,非细胞类,霉菌等,原生生物,类病毒等,培养基,无菌技术,基本成分,1碳源等内容,欢迎下载使用。
这是一份高中生物人教版 (2019)选择性必修3微生物的基本培养技术评课课件ppt,共26页。PPT课件主要包含了问题探讨,无细胞结构生物,原核生物,真核生物,培养基的配置,3培养基的类型,培养基的配制,自养微生物,异养微生物,无菌技术等内容,欢迎下载使用。
这是一份人教版 (2019)选择性必修3微生物的基本培养技术教学课件ppt,共44页。PPT课件主要包含了酵母菌的纯培养,1原理,2材料用具,①配制培养基,3方法步骤,②灭菌,③倒平板,课堂练习,培养基,高压蒸汽灭菌等内容,欢迎下载使用。
相关课件 更多
- 1.电子资料成功下载后不支持退换,如发现资料有内容错误问题请联系客服,如若属实,我们会补偿您的损失
- 2.压缩包下载后请先用软件解压,再使用对应软件打开;软件版本较低时请及时更新
- 3.资料下载成功后可在60天以内免费重复下载
 免费领取教师福利
免费领取教师福利







.png)




